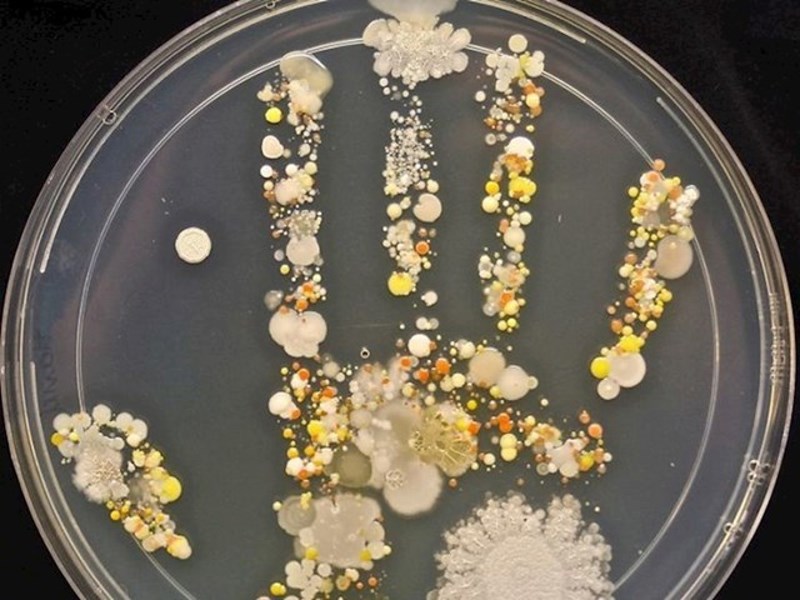
Otisak ruke osmogodišnjaka u Petrijevoj zdjelici

Razno
• 7 studenoga 2023
Ljudi su podijelili neobične stvari koje su im se slučajno dogodile

20K
Foto: BoredPanda/Reddit
Nije tajna da su neke od najvećih stvari u ljudskoj povijesti otkrivene posve slučajno, kao što su penicilin i rendgenske snimke.
I u svakodnevnom životu ljudi otkriju prilično cool stvari za koje nisu znali, ili ih nisu očekivali u tolikoj mjeri. Pogledajte neke od najzanimljivijih otkrića koje su ljudi doživjeli i odlučiti to podijeliti sa svijetom.
I u svakodnevnom životu ljudi otkriju prilično cool stvari za koje nisu znali, ili ih nisu očekivali u tolikoj mjeri. Pogledajte neke od najzanimljivijih otkrića koje su ljudi doživjeli i odlučiti to podijeliti sa svijetom.
#1 Ovo se dogodi kada munja pogodi pijesak na plaži

#2 Evo što se dogodi kada ostaviš polovicu kupusa predugo u hladnjaku

#3 Ovo se događa kada zagrijete mramor na plamenu, a zatim ga odmah spustite u hladnu vodu

#4 Otisak ruke osmogodišnjaka u Petrijevoj zdjelici
#5 Bundeva uzgajana u plastičnom kalupu

#6 Evo što se dogodi kada žaba pojede krijesnice

#7 Ovim svijećama je vruće

#8 Što se dogodi kada zaspite u kadi

#9 Ovo se dogodi s hranom na Antarktici na -70°C

#10 Što se dogodi kada bicikl predugo stoji vani

#11 Automobilska guma koja je prešla preko crteža od krede

#12 Pjena koja curi iz autopraonice

#13 Ovo je sirovo jaje koje je bilo uronjeno u vinski ocat 24 sata, zatim isto toliko u kukuruzni sirup i zatim u destiliranu vodu 24 sata

#14 Što se dogodi s površinom vode kada je jako hladno

#15 Ovo se dogodi kada ispolirate kokosov orah

#16 U ovoj dvorani su pukle cijevi

#17 Napušteni brod u Frankfurtu

#18 M&M bomboni u vodi

















